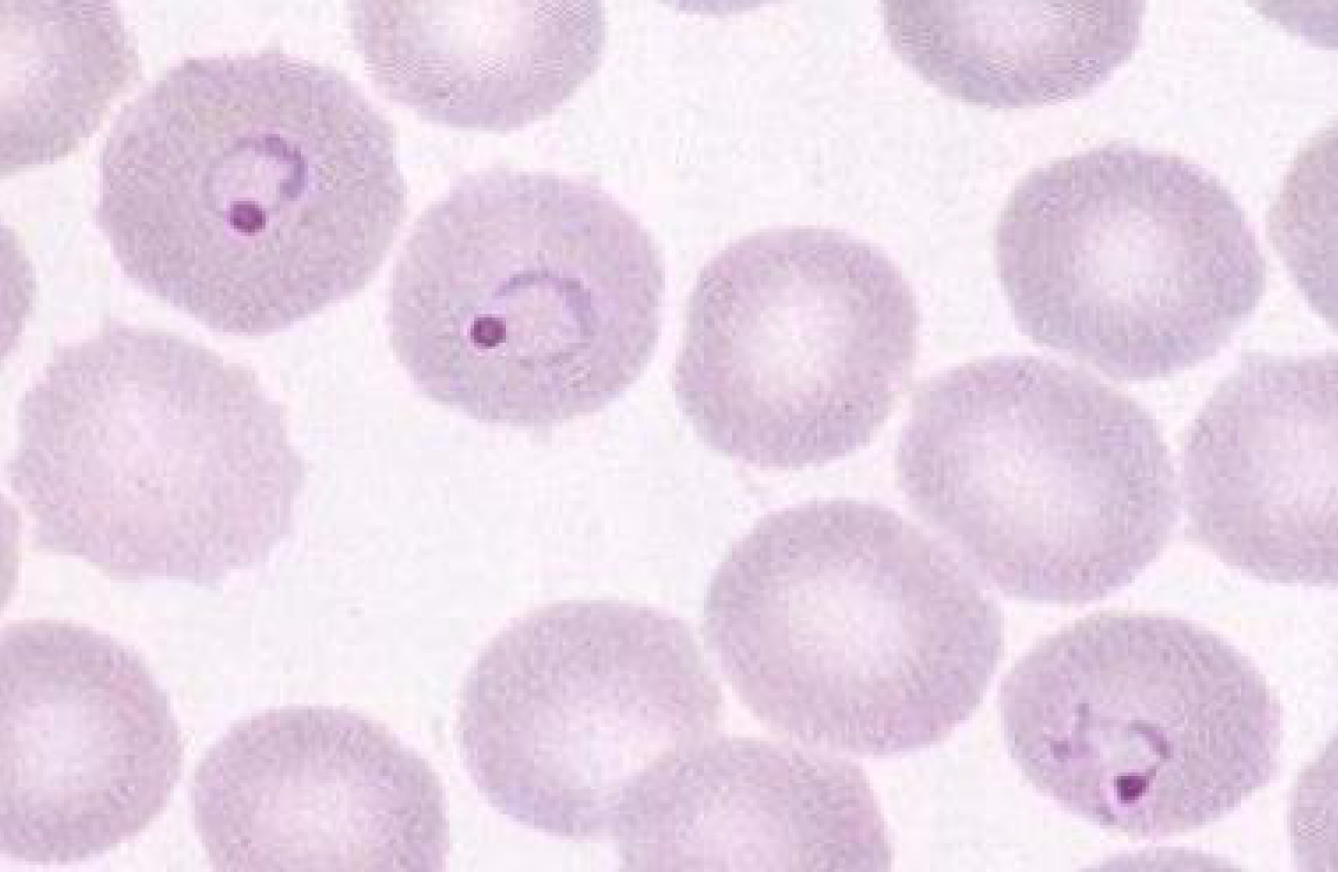

[기종평21]
0
여기에 표시한 문제들은 마이노트에서 모아볼 수 있어요!
21세 남자가 4일 전부터 열이 난다고 병원에 왔다. 4일 전부터 두통과 근육통이 약간 있었고 2일 전에 심한 오한 후 열이 났다가 괜찮아졌는데 오늘 다시 오한이 나고 열이 난다고 한다. 해외여행을 다녀온 적은 없으며 경기도 연천지역에서 군인으로 복무 중이고 현재 휴가를 받아 나 왔다고 한다. 말초혈액펴바른표본 결과이다. 원인 병원체는?
정답률 90%
누적 풀이 횟수 200+
평균 풀이 시간10초
/
나의 풀이 시간0초
해설
• 말라리아를 일으키는 열원충은 4가지로 분류된다 - 열대열원충, 삼일열원충, 사일열원충, 난형열원충. 우리나라에 서식하는 종은 삼일열원충(Plasmodium vivax)으로, DMZ 근처에 사는 군인, 마을 주민에게서 주로 발생한다.
• 전 세계에 분포하고 있는 가장 흔한 말라리아 형태로 48시간 주기로 열이 나는 것이 특징이다. 발열 이외에도 두통과 구역, 오한, 근육통과 같은 비특이적 증상이 나타난다. 모기 중에서 암컷 학질모기에 물려 감염된다.
추가 설명
• 열원충은 sporozoite 형태로 체내에 들어와 간으로 이동, 간세포 내에서 분열 증식한 후 merozoite 형채로 나오게 된다. 이후 적혈구에 들어와 고리 모양의 trophozoite 형태로 분열한 뒤, 다시 merozoite가 되어 적혈구를 파괴하며 빠져나온다. Merozoite의 일부는 암수가 구분되는 gametocyte이 되어 모기 체내로 들어가게 된다.
• 사진 자료는 적혈구와 그 안의 trophzoite를 보여주고 있다.
관련 이론
• 말라리아